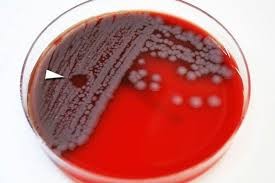

Une enquête indépendante diligentée par le Pentagone n'a identifié aucune faute majeure après l'envoi involontaire de bacilles actifs de la maladie du charbon (anthrax) vers plusieurs destinations par un de ses laboratoires en avril dernier.
«Une cause claire pour expliquer l'envoi d'échantillons actifs du bacille du charbon n'a pas pu être identifiée. Les personnels du département de la Défense semblent avoir suivi leurs protocoles correctement», indique le rapport de la commission d'enquête rendu public jeudi par le Pentagone.
Les échantillons actifs envoyés par inadvertance venaient du laboratoire militaire américain de Dugway (DPG), dans l'Utah (ouest). «Nous savons à présent que durant la dernière décennie 86 installations aux Etats-Unis et dans sept autres pays ont reçu de petites quantités de bacilles du charbon actifs, que le DPG pensait avoir inactivés», poursuit le rapport d'enquête de 37 pages.
Toutefois, soulignent les enquêteurs, il n'y avait pas de risques pour le public en raison des faibles concentrations de bacilles et personne n'a été contaminé. Un point clé qu'a découvert le comité d'enquête est «le manque d'informations techniques dans la communauté scientifique en général sur les protocoles d'inactivation des bacilles».
Ce manque d'éléments de référence a conduit chaque laboratoire à mettre en place ses propres protocoles, qui n'assurent pas systématiquement la stérilisation et l'inactivation des bacilles de manière efficace, poursuit le rapport. Le laboratoire DPG teste ses bacilles après irradiation pour vérifier qu'ils ont bien été inactivés, mais des échantillons trop petits sont testés, et ils sont vérifiés trop rapidement après l'irradiation.
«Il est clair que les spores des bacilles sont particulièrement difficiles à tuer, et des spores encore vivants seulement blessés par l'irradiation peuvent être en mesure de se réparer après quelque temps», souligne le rapport.
Cela peut expliquer pourquoi des bacilles jugés inactifs à la sortie du laboratoire ont pu être considérés actifs quelques semaines plus tard. Plusieurs recommandations sont adressées par le rapport.
«Si les laboratoires de recherche doivent avoir une certaine flexibilité pour explorer les limites de la science, les installations de production doivent opérer avec des procédures fiables et standardisées pour s'assurer de la qualité des échantillons.
Pour des opérations répétitives comme l'inactivation (...) des procédures communes doivent être appliquées». Le Pentagone a pour le moment institué un moratoire sur ces envois.
L'anthrax fait partie des bactéries mortelles potentiellement utilisables militairement parce ce qu'il peut être facilement disséminé sous forme de spores, sans que les populations cibles ne s'en aperçoivent.















